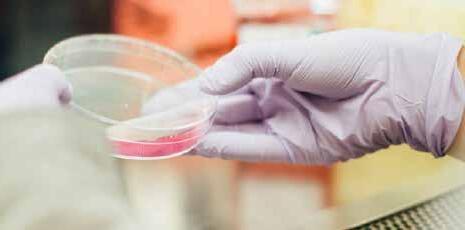

![]()

Dr. Warraich obtained her medical degree at the University of Manitoba. She then went on to complete a Royal College of Physicians and Surgeons accredited fellowship in Reproductive Endocrinology and Infertility at the Ottawa Fertility Centre in Ottawa, Ontario. She returned home to Winnipeg in 2018 to join Heartland Fertility and Gynecology Clinic as an associate physician. Dr. Warraich is committed to using her expertise to support patients at Heartland Fertility Clinic in achieving their dreams of family. She is fluent in English, Punjabi and Hindi.
EXPERIENCE STATE-OF-THE-ART FERTILITY CARE IN THE HEART OF MANITOBA
At Heartland Fertility, you’ll find a balance between exceptional facilities and a warm, caring team that combines advanced medical expertise with a genuine dedication to help you on your path to parenthood.

FERTILITY TESTING

IN VITRO FERTILIZATION (IVF)

EGG FREEZING

INTRAUTERINE INSEMINATION (IUI)


LGBTQ2SIA+ FAMILY PLANNING

DONOR & SURROGACY SOLUTIONS
HEARTLAND FERTILITY WELCOMES SELF-REFERRALS. REQUEST YOUR APPOINTMENT
HEARTLAND FERTILITY WELCOMES SELF-REFERRALS. REQUEST YOUR APPOINTMENT ONLINE


Dr. Shuvo Ghosh is a dedicated developmental pediatrician whose clinical, academic and research work centres on supporting children, youth and families in navigating some of the most complex challenges of growth, behaviour, identity and wellbeing. He obtained his undergraduate degree in Biology and Hispanic/Italian Linguistic Studies at Johns Hopkins University in Baltimore, followed by his medical degree from University of Illinois at Chicago College of Medicine. He then completed his residency in Pediatrics at Georgetown University in Washington, D.C., as well as rotations and research at University of Hawai’i - Mānoa and the Kewalo Marine Mammal Research Laboratory in Honolulu, HI. He subsequently pursued a fellowship in Developmental-Behavioural Pediatrics at the Montreal Children’s Hospital at McGill University in Montreal, QC.
In his current roles, Dr. Ghosh serves as Director of the Developmental Pediatrics Program at McGill University, within the Division of General Pediatrics. He co-directs the Gender Variance Clinic (GVC) at the Montreal Children’s Hospital, where he is the medical lead of the Brain, Development, and Behaviour Clinical Network. He is a

co-director of the community-based Meraki Health Centre which focuses on marginalised populations, where he has helped to pioneer clinical and research work at the intersection of child development, gender identity, and health equity.
Dr. Ghosh’s research interests span various areas including: nutritional influences on development, issues affecting language acquisition, the pathways of gender development and variance, infant soothing and crying behaviour, the ethics of access to developmental interventions,as well as the psychophysiologic underpinnings of brain development and behaviour. Among his published works are explorations of the communication between pediatricians and psychologists in ADHD, and measures of psychological distress following paediatric critical illness. He is deeply committed to working collaboratively with children, their families and communities in the framework of whole person health care: a holistic approach to caring for others. He sees hisdaily interactions not simply as clinical work, but as an ongoing conversation about how we care for ourselves, our children and society more broadly.
Beyond the clinical and academic spheres, Dr. Ghosh brings a creative and human dimension to his practice: he speaks 11 languages in varying degrees of fluency, is a writer of poetry, narrative non-fiction and fiction, and as a musician he leads his own Montreal indie-pop band, Hearts Underground.



As we unveil another vibrant issue of Manitoba South Asian Health Magazine, we are reminded of the deep cultural and spiritual significance of this season. The joyous celebrations of Diwali and Bandi Chhor Divas remind us of the enduring power of light over darkness, hope over despair, and unity over division. These festivals hold a special place in South Asian hearts, symbolizing renewal, strength, and the triumph of goodness—values that also guide our publication’s mission to uplift and inspire our community.
This year, we are delighted to spotlight the Asian Women of Winnipeg (AWOW) and their upcoming Diwali Celebration Dinner & Dance taking place on Sunday, October 26, 2025, at the Punjab Culture Centre (1770 King Edward St.) from 5 pm to 10 pm. The event promises an evening filled with culture, music, and community spirit. We encourage everyone to stay connected with AWOW, as this dynamic group continues to host empowering and inclusive events throughout the year that strengthen our South Asian community in Manitoba.
Our feature cover story for this issue—“From Stress to Strength: Dr. Gurinder Randhawa on Turning the Immigration Journey into a Growing Pathway for Wellness and Empowerment”—shines a light on the vital connection between health, wellness, and immigration. As the founder of Growing Pathways Immigration, Dr. Randhawa has dedicated her work to guiding newcomers through what can often be a stressful and uncertain process. Her compassionate, holistic approach not only helps individuals navigate immigration policies but also empowers them to embrace emotional resilience, mental well-being, and community belonging as part of their journey to a better life in Canada. Looking ahead, our next feature will highlight Dr. Warraich from Heartland Fertility, whose expertise in reproductive endocrinology and infertility offers hope to many families. Studies show that infertility affects approximately 1 in 6 Canadian couples, and within the South Asian community, cultural stigmas can add emotional challenges to an already sensitive issue. Through awareness and medical innovation, professionals like Dr. Warraich are helping couples build families and restore balance to their health and happiness.
As we celebrate this festive season of Diwali, let us be reminded of the significance of light conquering darkness, both in our personal lives and within our communities. May the glow of the diyas bring joy, health, and prosperity to you and your loved ones. In the spirit of new beginnings that Diwali represents, our team is also thrilled to announce the launch of the South Asian Health Magazine in Quebec and California. We are in the process of a global expansion, and these are truly exciting times ahead as we continue to share stories of health, success, and empowerment with South Asian communities around the world.

Wishing all our readers a Happy Diwali and Bandi Chhor Divas!





Catch up on immunizations!
Vaccines save over 3.5 million lives per year by preventing common diseases and illnesses. Vaccines are tested and rigorously reviewed before being approved. They are among the safest medical interventions available.
Get a personalized check list about which vaccines are recommended for you and your family at GettingHealthy.ca. Getting a vaccine is your choice, and a doctor can answer your questions to help you make the best choice for your health.
is a unique book that helps children address bullying and overcoming fear by believing in themselves.

Sometimes, the most fascinating part of a book is the story behind it. For me, this book is deeply personal—an account of my own healing journey behind the scenes. It’s not just a story for children, but a reflection of my experiences and the resilience I discovered along the way. This book has been a lifelong dream. Ever since I was a young girl, I promised myself that one day I would write it. What I didn’t anticipate, however, was that when the time finally came, I would face an unexpected challenge—a mild traumatic brain injury left me unable to read or write. What makes this book so special is its message—it’s more than a story. It teaches children about self-love, selfawareness, and cultivating the courage from within. By helping children understand their worth and strength, this book offers tools to combat bullying and build confidence. These lessons are not just for the playground but for life.
Through storytelling, I found a way forward. Even though I struggled to read and write, I leaned on the fact that our brains are natural storytelling machines. Storytelling is not only medicinal, but it is also profoundly healing for mental health. It gave me the strength to endure one of the most difficult times in my life.
Storytelling helped me process my emotions, reduce feelings of isolation, and create a sense of purpose and meaning in my journey. It allowed me to reframe my struggles, giving me a sense of control over my narrative and enabling me to see myself as resilient instead of broken. This act of sharing and reshaping my story became a key part of my healing process.
My memory became my greatest ally. Despite my limitations, I used it to piece together my ideas and, over time, I gained the skills to read and write again. I transitioned from editing in my mind to editing on paper, a process that felt transformative.
Storytelling is a beautiful way to reclaim and rearrange the narrative you’re in and change the outcome of your experience.
Storytelling also illustrated to me the power of creativity and healing.



Mamta is so excited for her first day of grade three! But when her classmates start to whisper and laugh in the line for recess, Mamta wonders if she’ll ever fit in. With some help from her Ma, Mamta learns to celebrate who she is in a confident and sparkling way. As Mamta encourages her classmates to shine bright and share their differences, she gains self-confidence and makes a new and unexpected friend. The book is available on: www.pujatheauthor.ca Amazon www.indigo.ca
Puja Suri is a Canadian Certified Counselor, Mind and Body Coach and Children’s Yoga Instructor. She has a passion for inclusion and has spent many years advocating for people with disabilities. In 2016, she was awarded the Certificate of Appreciation by Vantage for her valuable contributions within her community. Puja is the founder of Seva Girl, a fundraising-based initiative that supports organizations that educate and empower women and children. Her love for self-acceptance is incorporated in Mamta’s Lovely Mustache, which is based on her life, but with a fun twist.





You have a rich academic background as a professor and educator before becoming a Regulated Canadian Immigration Consultant. Can you share what inspired you to transition into the immigration field?
Throughout my teaching career, I have had the privilege of mentoring countless students, many of whom are newcomers to Canada. In my current role at an inner-city school— where about 80% of students come from immigrant families—I have witnessed firsthand the challenges they face in adapting to a new culture, education system, and society.
As an immigrant myself, I deeply understand their struggles and the importance of having the right guidance.

I feel truly delighted and proud when I see my clients place their trust in me and successfully reach their dream destination— Canada. It gives me immense satisfaction to play a role in turning their dreams into reality
My transition into immigration work began in 2016, when I started organizing beauty pageants and children’s talent shows under my non-profit organization-Shining Star Productions Manitoba. While applying for visitor visas for international guests and celebrities invited to these events, I became increasingly inspired to formalize my involvement by becoming a Regulated Canadian Immigration Consultant.
In 2019, I completed an Immigration Practitioner Diploma in Immigration Laws, Policies, and Procedures and obtained my RCIC license to start my own practice. Later, I pursued further specialization in Immigration and Refugee Board (IRB) procedures, which now allows me to represent clients before the ID, IAD, RPD, and RAD divisions of the IRB. Combining my academic foundation, cross-cultural understanding, and personal immigrant experience, I am proud to help individuals and families navigate their pathways toward a successful life in Canada.
For me, the transition wasn’t so much a shift as it was an expansion of my passion for empowering others. Whether in the classroom, through pageants, community service or through immigration services, my goal has remained the same: to help people succeed, feel supported, and build meaningful futures. I feel truly delighted and proud when I see my clients place their trust in me and successfully reach their dream destination—Canada. It gives me immense satisfaction to play a role in turning their dreams into reality.
Growing Pathways Immigration has become a trusted name in the community. What personal experiences or values motivated you to build a career helping families navigate such an important and often stressful journey?
Growing Pathways Immigration was born out of both personal experience and a strong sense of responsibility to give back to the community. As an immigrant myself, I know how overwhelming and stressful the process can be, from navigating applications, policies, to the uncertainty of not knowing what the future holds. That experience shaped my empathy and gave me a deep understanding of what families go through.
My values of compassion, integrity, and community service have always guided me, whether in education or immigration. I wanted to create a place that was more than just a business, rather a place where people felt supported, heard, and respected at every step of their journey. That’s why trust and transparency; clear and honest communication is at the core of Growing Pathways Immigration. For me, every file is someone’s dream, someone’s family, and someone’s future with which you cannot compromise at any cost.
As someone who has lived and worked in both India and Canada, how has your own personal journey shaped the way you guide and support South Asian families through the immigration process?
Having lived and worked in both India and Canada, I bring a unique perspective to supporting South Asian families. Not only south Asian families, I provide immigration services to people from any country and community. I understand the cultural values, family dynamics, and aspirations that often guide their decisions, as well as the challenges they face when transitioning to life in Canada.
My own journey of moving from India to Canada taught me that immigration is not just about documents but about rebuilding your life in a new environment, integrating in the new environment, accepting the new system while holding on to your roots. Because I have experienced this myself, I can empathize with the uncertainties, sacrifices, and hopes that come with the process.
This understanding allows me to guide families not only with professional expertise but also with cultural sensitivity and emotional support. I take pride in bridging the gap between Canadian systems and South Asian expectations, ensuring families feel respected, understood, and confident as they start their new chapter in Canada.
Immigration is often described as one of the most stressful life experiences for families. From your experience, how does the immigration process impact the mental and emotional health of South Asian families in Canada?
Immigration is one of the most stressful transitions a family can go through, and for South Asian families in particular, the emotional and mental toll can be significant.


Many come with high hopes and expectations, but the reality of separation from loved ones, cultural adjustment, and uncertainty about the future can create stress, anxiety, and even feelings of isolation. It’s very hard for some to face the cultural, social and economic shock.
In South Asian culture, family bonds are very strong, and being apart from parents, children, or siblings often weighs heavily on people. I’ve seen cases where individuals carry a deep sense of guilt or worry because they can’t support their families back home as much as they’d like. Others struggle with identity and belonging, balancing traditional values with Canadian ways of life. Others felt very isolated because they have nobody to talk to.
This is why I approach my work with empathy and patience. By guiding clients through the process with clarity, honesty, transparency and cultural sensitivity, I try to reduce some of that stress and provide reassurance. Sometimes, simply knowing that someone understands their struggles makes the journey a little lighter. Emotional and mental well-being should be the priority. Living alone far way from your loved ones and starting life from scratch is not easy.
Family reunification is one of the most emotional aspects of immigration. How do you see the process of bringing loved ones together affecting the overall wellbeing of South Asian families?
Family reunification is one of the most powerful and transformative aspects of immigration. For South Asian families, where relationships and intergenerational bonds are at the heart of life, being reunited with loved ones brings a profound sense of relief, joy, and stability. It often restores emotional balance, reduces loneliness, and strengthens family support systems, which are essential for overall well-being.
I’ve seen firsthand how parents feel more at peace when their children are close by, and how newcomers gain confidence and motivation when they have family around them. It not only improves emotional health but also contributes to economic and social stability, because families can support each other in practical ways, whether it’s childcare, finances, or simply having someone to share everyday life with. It can be extremely stressful for international students juggling late-night shifts along with their studies, or for workers managing two or three jobs a day just to make ends meet.
For South Asian families, reunification is about rebuilding the sense of “home” they left behind. And when that happens, families are better equipped to thrive in Canada, both emotionally and socially.

My first advice is to stay informed,understanding theprocess,timelines, andrequirementscan reduce a lot of the anxiety that comes from uncertainty
Lengthy processing times or refusals can take a toll on families. What advice do you give clients to help them manage stress and maintain hope during these uncertain times?
Lengthy processing times and refusals are incredibly difficult for families, and I always acknowledge that the stress they feel is valid. My first advice is to stay informed, understanding the process, timelines, and requirements can reduce a lot of the anxiety that comes from uncertainty. I make it a point to keep my clients updated and explain every step clearly, so they don’t feel left in the dark.
I also encourage families to focus on what is within their control, such as ensuring their applications are complete, accurate, and strong. This way, they know they’ve done everything possible from their side.
At the same time, I remind them that delays or refusals don’t define their future, rather, are often just a matter of persistence and trying again with the right strategy.
On the emotional side, I recommend leaning on community support, staying connected with family members abroad, and engaging in activities that reduce stress. Hope is easier to maintain when people feel supported and connected.
Ultimately, I my role is not only to manage the legal process but also to be a source of reassurance, reminding families that setbacks are temporary and that with patience and persistence, success is still possible.
What
inspired you to start Shining Star Productions Manitoba, and how do you see arts and culture playing a role in promoting wellness and community connection among South Asian families
Arts and culture have a unique power to promote wellness and community connection. For South Asian families, participating in cultural events not only reduces feelings of isolation but also strengthens identity and belonging. Whether it’s through dance, music, pageants, or talent showcases, these events bring people together, bridge generations, and create joy.
I believe that when individuals have opportunities to express themselves creatively and celebrate their culture, it enhances mental health, builds resilience, and fosters stronger communities. That vision has always guided Shining Star Productions Manitoba.
The impact of Shining Star Productions Manitoba has been truly rewarding to witness. I’ve seen young people who were initially very shy, no confidence or uncertain step onto the stage and discover a new level of confidence in themselves. I have set up this platform for the beginners. That boost often extends beyond the event, helping them in school, in universities or colleges, social settings, and even in their future careers.
For families, participating in or attending these events creates moments of joy and togetherness that help reduce stress. It gives them a break from the pressures of daily life and immigration challenges, and instead allows them to celebrate milestones, traditions, and achievements as a community.
Most importantly, I’ve seen how the platform strengthens cultural pride. When youth perform dances, showcase music, or participate in pageants that highlight heritage, it reinforces their connection to their roots while also sharing their culture with the broader Manitoba community. This dual sense of pride and honoring where they come from while thriving in Canada, has a lasting impact on wellness and belonging.



Through your work with Shining Star Productions Manitoba and other community initiatives, you support youth and families. How important is community involvement for reducing stress and promoting wellness during the immigration journey?
Community involvement is absolutely essential during the immigration journey. Moving to a new country often comes with feelings of uncertainty, stress, and even isolation. Being connected to a supportive community provides newcomers with a sense of belonging and reassurance that they are not alone in their struggles.
Through initiatives like Shining Star Productions Manitoba, I’ve seen how community events create safe and welcoming spaces where youth can share experiences, celebrate culture, and build meaningful relationships. For youth, these opportunities help them make friends, build their network, develop confidence, feel empowered and proud of their identity. For parents, community involvement often eases stress by offering emotional support, practical resources, and a network they can rely on.
Women in South Asian families often carry a heavy emotional burden when navigating immigration stress. What unique challenges do you see them facing, and how can they prioritize their wellness during this process?
Women in South Asian families often carry the heaviest emotional and practical responsibilities during the immigration journey. Many juggles multiple roles: caring for children, supporting extended family, adjusting to a new culture, and sometimes entering the workforce for the first time in Canada. On top of this, they are often the emotional anchors of the family, managing everyone else’s well-being while neglecting their own.
Some of the unique challenges I’ve observed include isolation due to language or cultural barriers, difficulty balancing traditional expectations with new realities, and limited access to support systems and limited access to support systems—especially during major life transitions such as divorce or separation. These circumstances often lead to stress, anxiety, and a feeling of being “stretched too thin.”
Having personally gone through the divorce process and raising my daughter on my own, I deeply understand how difficult it is to make the decision to separate—especially coming from a culture where such choices are often stigmatized. Without parental or community support, the journey becomes even more painful. It takes immense courage and strength to walk away from a relationship after investing one’s prime years and every effort into making it work. Unfortunately, in many South Asian communities, divorce remains a taboo subject till today, not viewed as a normal part of life.
As a result, many women remain in toxic or abusive relationships, sacrificing their mental and emotional well-being, as well as that of their children.
I always encourage women to prioritize their wellness by seeking counselling, community connections, whether through cultural groups, women’s organizations, or faith-based networks. Taking time for themselves even in small moments for learning, hobbies, or self-care can make a big difference. It’s also important for them to know that asking for help is not a sign of weakness but a step toward resilience. When women feel supported and empowered, the whole family benefits. Their wellness strengthens not just their own journey but the collective success of their family in Canada.
Your daughter Bisman Randhawa has already achieved so much, including earning a scholarship—how has her journey inspired you personally and professionally?
My daughter Bisman has been a tremendous source of inspiration both personally and professionally. Despite being born with a visual impairment, she has faced every barrier with remarkable determination, transforming her challenges into strengths and inspiring everyone around her with her courage and optimism. Watching her going through visual impairment challenges, embracing challenges, pushing herself to break the barriers, working hard, and achieving success has reminded me of the importance of perseverance, resilience, and dedication— qualities that are equally essential in both life and my professional practice.

On a personal level, her accomplishments bring immense pride and joy, and they constantly remind me that guidance, encouragement, and belief in someone’s abilities can make a lasting difference. Professionally, it strengthens my commitment to mentoring, supporting, and advocating for others in their pursuits- just as I do for my daughter and my students.
As a single parent who has raised her daughter all by herself, how did you feel when she got University of Toronto national scholarship and TB bank national scholarship this year? How hard it was to choose between two scholarships as she cannot stack scholarships? Why did she choose the UofT full ride national scholarship?
As a single parent, watching Bisman receive both the University of Toronto National Scholarship and the TD Scholarship for Community Leadership this year was an incredibly emotional and proud moment for me. It felt like a celebration of our shared journey- of all the hard work, perseverance, and dedication we’ve both poured into her success—and a reflection of the values and guidance I’ve strived to instill in her as a parent.
Choosing between the two scholarships was challenging, especially since such prestigious scholarships cannot be stacked. Each offered incredible opportunities, so the decision required careful consideration of what would best support her long-term goals, academic growth, and personal development.
As a proud mother, accomplished woman, educator, community leader, volunteer, and immigration consultant, how have these multiple roles impacted your physical and mental health, and what strategies do you use to stay energetic and manage stress?
Balancing multiple roles; as a mother, educator, beauty pageants producer, community leader, volunteer, and immigration consultant can be both rewarding and demanding. Naturally, there are times when the responsibilities feel overwhelming, and it can take a toll on both physical and mental health.
To stay energized and manage stress, I prioritize self-care and maintain a structured routine. Yoga helps me release tension and stay focussed. I also believe in expressing self-love—whether through dressing up, shopping for myself, staying active, dining out, socializing, or simply taking time to feel good about who I am. Above all, I’ve learned to embrace both my successes and failures with humility, recognizing that each experience contributes to my growth and resilience.
Every role I take on aligns with my values, passion and purpose. Seeing the positive impact on my daughter, students, clients, and the broader community provides immense motivation and energy. Finally, I embrace flexibility and realistic goal setting, understanding that I don’t need to be perfect in every role at every moment. By combining passion, planning, self-care, and community support, I’ve been able to navigate a busy life while staying energized, focused, and fulfilled. At the end-health is wealth.
As both a mother and mentor, what lessons have you tried to instill in Bisman that you feel are important for other South Asian youth striving to balance success, well-being, and cultural identity?
As both a mother and mentor, I’ve always tried to instill in Bisman the importance of courage, resilience, balance, humility and staying true to her values. I’ve taught her to stand up for herself and to use her voice with confidence and purpose. I want her—and other South Asian youth—to understand that success isn’t defined solely by grand accomplishments, but also by the small, meaningful steps that pave the way toward those achievements. Equally important is nurturing emotional, mental, and physical well-being, maintaining strong relationships, and honoring one’s cultural roots and identity.
I emphasize the value of hard work, perseverance, and self-discipline, while also encouraging her to prioritize mental and emotional health. I want her to know that asking for help, taking breaks, and celebrating small victories are all part of a balanced approach to life.
Most importantly, I encourage her to embrace her cultural roots as a source of pride and strength, even while navigating new environments. For youth balancing multiple identities, this grounding in culture builds confidence and a sense of belonging. Through these lessons, I hope to show that it’s possible to achieve excellence, maintain wellness, and honor one’s heritage all at the same time—a valuable lesson for any young person navigating life in Canada today.
You’ve accomplished a lot at a young age, including earning a national scholarship to University of Toronto (#1 University in Canada). What drives you to work hard and stay focused on your goals? Which extra-curricular activities were you involved in your high school besides academics?
What drives me most is my curiosity to learn, experience, and understand more of the world around me. Earning a national scholarship to the University of Toronto wasn’t just about my commitment to academia, rather, it reflected years of curiosity and community involvement. In high school, I was deeply engaged in initiatives like Maples4Women, CoPresident of student council, Ambassador GeneralFolklorama, Youth Parliament (Currently, Minister of Alumni Affairs YPM), Page at Legislative assembly, where I led research and advocacy on issues ranging from gender equity to multiculturalism. These experiences taught me that learning doesn’t only happen in classrooms, but also in service, leadership, and collaboration.
I found that UofT had the most diverse opportunities and resources necessary for me to thrive and grow and used its rigorous and stellar reputation as a catalyst for me to further my curiosity and step into spaces I've never heard of.
Having a mother who is both an educator, community leader, volunteer and an immigration consultant must be inspiring. How has her journey influenced your own outlook on education, community, and success?
My mother has been my greatest teacher and mentor. Watching her balance roles as a single parent, an educator, pageants producer, community leader, volunteer, and immigration consultant showed me that education is the most empowering tool. Her commitment to helping her students, youth and
newcomers/immigrants and her constant drive to give back have shaped my own understanding of success, as a form of collective growth. She taught me that pursuing your passion, community work, team work and compassion are forms of leadership just as vital as academic excellence, and when combined serve as the greatest outlets of service. She also taught me that my emotional, mental and physical well-being should be my priority.
Many young people in the South Asian community balance cultural expectations with personal aspirations. How do you manage that balance while pursuing your academic and personal goals?
Like many South Asian youths, I’ve had to navigate the space between tradition and individuality. I’m proud of my Sikh heritage as it grounds me in values of seva and learning, but I’ve also learned to define success in my own way. I honor my roots while exploring new paths, like moving to Toronto (leaving my mom and my home- my comfort zone) to study diaspora and public policies and exploring multiculturalism and globalization, which connect my identity to the world around me.
What message would you share with other South Asian youth about staying motivated, managing stress, and striving for excellence while taking care of their well-being?
Motivation doesn’t come from pressure; it comes from passion. I encourage every youth to seek passion within their pursuits, as success is sweeter when you care about what you do. Our community has so much talent and resilience, and I believe we thrive when we support one another instead of comparing our achievements. I hope that us kids learn to stay grounded in who we are, and continue to stay motivated intrinsically, as the most powerful thing you can do is show up as your full, authentic self.
(ISDMT) is a premier institution dedicated to preserving and promoting the rich visual, literary, and performing arts of India in Canada. Based in Winnipeg, Manitoba, ISDMT offers after-school programs that provide rigorous training in classical Indian arts while also catering to a broader audience through its recreational streams. These include Folk Dances, Devotional Music, Bollywood Dance, Yoga, and Theatre—allowing students to explore performances relevant to their age, experiences, and contemporary times.

As a multidisciplinary arts institution that unites dance, music, and theatre under one umbrella, ISDMT is a unique entity in Canada and North America. The school takes pride in its esteemed faculty, which includes Gurus and instructors from across Canada, as well as internationally recognized artists from India and beyond. Their expertise, artistic vision, and commitment to excellence shine through in ISDMT’s recitals and showcases, where local talent blends seamlessly with world-class instruction.
www.indiaschool.ca




What inspired you to establish the Functional Health Institute, and how has your personal Journey shaped your approach to functional
so I thought), working out, and doing everything I was told to do, but I was getting sicker, not better.
The turning point came when I realized that the answers I was searching for weren’t going to come from treating


The Functional Health Institute was born out of that mission to help people reclaim their health by working with their bodies, not against them. We don’t chase symptoms. We uncover root causes. We d on’t use one-size-fits-all protocols. We honor each person’s unique physiology, history, and story to create a bespoke healing journey.
How do you define “functional health” and how does it differ from conventional medical models in terms of patient care?
To me, functional health is all about health creation. It’s about asking why the body is out of balance, rather than just figuring out how to suppress symptoms. It’s about working with your biology, not overriding it.
Functional health sees the body as a connected, intelligent system where symptoms in one area often have roots in another. That means we don’t just look at where it hurts, we look at why it’s happening in the first place. Is it gut dysfunction? Hormonal imbalance? Mold exposure? Nervous system dysregulation? Toxicity?
We dig deep and tailor the plan around your unique biology and history.
gives people what they’re truly seeking: a path back to their energy, vitality, and quality of life.
That’s where functional health shines. Instead of a quick fix or a one-size-fits-all solution, we guide people through a personalized process of restoring balance, supporting their body’s natural healing mechanisms, and empowering them to become active participants in their own transformation.
Your practice emphasizes “root cause”. Can you walk us through how you work with a patient?
At the Functional Health Institute, our process isn’t about chasing a diagnosis — it’s about discovering why a person’s body is struggling and what’s standing in the way of their healing. We’ve built our model around three key pillars: Foundations, Details, and Results.
We don’t chase symptoms. We uncover root causes. We don’t use one-size-fits-all protocols. We honor each person’s unique physiology, history, and story to create a bespoke healing journey
Now, it’s important to say that conventional care plays a vital and instrumental role in our healthcare system. It’s the most effective and efficient model for acute health issues — trauma, infections, surgeries, and emergencies. It saves lives. But when it comes to chronic conditions — the kind that leave people saying, “I just don’t feel like myself” — our current system often falls short. It’s now overwhelmed by the growing burden of chronic illness, yet rarely
We start with the foundations, because without a strong foundation, nothing else sticks. This means guiding our patients to build a lifestyle that supports health creation, not just symptom management. We address how they eat, not just what they eat. We dive into sleep quality, nervous system regulation, mindset, movement, environmental stressors, and even the health of their relationships. We teach them how to align their daily habits with a healthier version of themselves, where it matters most: in their home and routines.
Once we’ve built that foundation, we move into the details. This is where we use functional lab testing to uncover hidden stressors that often go overlooked.
These might include mold mycotoxins, stealth infections via stool, environmental toxins, heavy metals, genetics, or chronic inflammation, and so much more. These are things we can’t see, touch, or feel, but they are powerful forces that quietly erode a person’s health.
Finally, we bring the two together to deliver results by layering personalized insights from lab testing onto a life that’s now ready to heal. This is where real transformation happens, because we’re not just handing someone a protocol, we’re giving them a process that honors their biology, their story, and their uniqueness.
How do you integrate conventional medicine with Functional Medicine?
Functional health integrates seamlessly with conventional care by filling in the gaps — it doesn’t compete, it complements. While conventional medicine is excellent for diagnosing and managing disease, functional health goes deeper to understand why dysfunction is happening in the first place and how to restore balance across the whole body.
Think of conventional care as putting out a fire, while functional health focuses on rebuilding the house, making it stronger, safer, and more resilient than before. But rebuilding takes intention. That’s why the client plays an active role in learning,

implementing, and staying engaged in the process. Because lasting healing isn’t something done to you — it’s something built with you.
Many South Asians in Canada face a higher risk of chronic conditions like diabetes, heart disease, and metabolic syndrome. What unique factors do you see contributing to these trends, and how does the Functional Health Institute tailor its care to meet the specific needs of this community?
It’s true that, as South Asians, we carry a statistically higher risk for metabolic conditions, but it’s not just about genetics. The two biggest health concerns in our community are type 2 diabetes and cardiovascular disease, both rooted in poor metabolic health. What I see most often is a growing mismatch between our cultural identity and our modern life style.
As South Asians, we come from a rich heritage steeped in spirituality and practices deeply connected to nature, community, and purpose. These traditions weren’t just beneficial; they were functional, supporting digestion, nervous system balance, and emotional regulation.
But in today’s fast-paced world, we’ve drifted away from that wisdom and traded it in for the high-pressure, convenience-first lifestyle of the West. Reclaiming health means more than taking supplements or tracking numbers. It means reconnecting to a deeper purpose and building a life that supports health at its roots — in how we eat, sleep, move, think, and relate to others.
That’s why we created the Inspired Living Metabolic & Lifestyle Reset Program , designed specifically to target the root causes of these chronic conditions.
Through this program, we guide you in:
nBalancing blood sugars and hormones so energy and mood stabilize naturally.
nLowering inflammation to protect heart health and improve circulation.
nShedding 20–40 pounds of excess weight in just 6 weeks (and keeping it off) through sustainable, enjoyable changes.
nRestoring digestive health and deep, restorative sleep so your body can repair each night.
nImplementing powerful stress-regulation techniques like breathwork to calm the nervous system and support healing.
We’ve seen incredible transformations — not just in lab results, but in energy, confidence, and quality of life. We’ve had type 2 diabetics reverse their condition entirely, with their primary care physicians taking them off medications. We’ve seen women in perimenopause finally lose stubborn weight after years of frustration. Patients who once struggled with constant brain fog now enjoy mental clarity and sharpness, along with renewed energy and passion for life. And while supplements and testing have their place, the real magic happens when people learn how to live in a way that consistently supports metabolic health for the long term.

At the Functional Health Institute, we also weave cultural wisdom into the healing process. One powerful example is teaching proper breathing techniques, a foundational practice for calming the nervous system and shifting the body into a healing state. Many of us, myself included, have unknowingly developed dysfunctional breathing habits that keep us stuck in fight-or-flight mode, limiting the body’s ability to repair and restore. Relearning how to breathe is often one of the first, and most transformative, steps.
And perhaps most importantly, we acknowledge that healing is an active process. We can’t expect these complex issues to resolve passively. The patient is the most important factor in the healing process. It takes aligned effort — effort that becomes joyful and sustainable when it’s rooted in your unique purpose and identity.
Functional Health Institute integrates advanced diagnostic tools. Can you share how these tools enhance the accuracy and depth of your assessments?
At the Functional Health Institute, we use advanced diagnostic tools not to chase a diagnosis, but to uncover why the body is no longer expressing health the way it should.
These tools go far beyond basic blood work, they allow us to detect hidden stressors like mold toxins, gut infections, nutritional deficiencies, and chronic inflammation before they manifest as diagnosable disease. We look at things that conventional testing often misses, such as how your body is functioning on a cellular level, how it’s metabolizing nutrients, managing toxicity, or responding to chronic stress.
This gives us a much deeper, more precise understanding of what’s truly going on beneath the surface, and it allows us to personalize every part of the healing process. Rather than guessing or taking a one-size-fits-all approach, we work with real data that reflects the uniqueness of your biology and your lived experience.
Are there any new therapies or technologies in functional medicine that you’re particularly excited about right now?
What excites me most right now isn’t just a specific test or supplement; it’s the way we can now see what’s really going on beneath the surface and teach people how to influence it themselves.
The game-changer for me has been the ability to assess nervous system regulation, specifically through heart rate variability (HRV).
HRV is a measure of how flexible and resilient your nervous system is. It’s not about how fast your heart beats — it’s about how well it adapts. A higher HRV means you’re more balanced, adaptable, and in a better state to heal. A chronically low HRV tells
us that the body is stuck in fight-or-flight, making healing almost impossible, no matter how many supplements you take.
That’s why I love using HeartMath and other HRV biofeedback tools in our programs. They allow us to teach our clients how to improve their own nervous system tone through breathwork, coherence training, and emotional regulation. It’s incredibly empowering to help someone see that they have the ability to shift their biology in real time.
At the Functional Health Institute, we’re not just handing out protocols; we’re teaching clients how to understand their bodies, interpret feedback, and make intentional changes that support healing at the deepest level.
Because the truth is, healing doesn’t come from a pill. It comes from alignment — in biology, in behavior, and in belief. And HRV is one of the clearest mirrors of that alignment.
Nutrition, sleep, and stress management are foundational pillars in our programs because they directly impact the body’s ability to heal, regulate inflammation, and maintain overall balance.
To help clients make sustainable lifestyle changes, I focus on education, self-awareness, and small, manageable steps that fit into their daily lives. I emphasize tools they can implement themselves— such as tracking heart rate variability to better understand their stress response, mindful breathing, and gradual dietary shifts so that change feels achievable, not overwhelming. Ongoing support, accountability, and celebrating small wins are key to transforming these habits into lasting improvements.
Looking ahead, what is your vision for the future of integrative health care in Canada, and how do you see your work contributing to that shift?
I believe the future of health care in Canada will be shaped by a powerful shift, one where people move from being passive recipients of care to active
participants in their own healing journey. If we don’t engage the individual as the driving force behind their health, we’ll never see the life-changing outcomes that are truly possible.
My vision is to help people reclaim their power and reconnect with the incredible healing potential built into their bodies. I want to move the conversation away from “What pill do I need?” and toward “What is my body trying to tell me, and how can I support it?” This shift transforms health care from a reactive, symptom-chasing system into a proactive, lifeenhancing one.
When people learn that true healing requires intention, selfawareness, and a willingness to make meaningful changes — in how we live, eat, sleep, breathe, move, and think — something remarkable happens. They stop feeling broken or limited by a diagnosis, and they start stepping into their own greatness.
It’s no surprise that you often see celebrities adopting these concepts early on. People like Tim Robbins, Kim Kardashian, Dana White, and so many others are embracing a root cause, Functional Health approach to ensure they can not only feel their best but also look and perform their best for years to come. This level of proactive care is something I believe should be available to — and embraced by — everyone, not just those in the public eye.
Through my Inspired Living Metabolic and Lifestyle Reset Program and my Essentials 1-on-1 Functional Health Program, I’m guiding people through transformations that often exceed what they thought was possible, reversing chronic disease, restoring energy, lifting brain fog, and reigniting joy for life.
Beyond my programs, my mission is to keep spreading this message through ongoing education on social media and, soon, a podcast that will serve as a hub for learning, inspiration, and empowerment. I envision a ripple effect where these ideas become more mainstream. And Canadians of all ages start to see health not as something they “manage,” but as something they actively create and protect every single day.
Because when patients become true partners in their care, health care stops being about just living longer… and starts being about living better.




•


Seniors, infants, children and families are all relying on your generosity to make it through the day. Wages, rent and rising grocery prices are putting a daily strain on the lives of so many in our community.

Please consider a one-time donation, a legacy gift, volunteering or becoming a monthly donor.

The holiday season adds extra stress to society’s most vulnerable. Please donate today.
Watch this video and see the di erence your donation can make.













What inspired you to start The Fit Kitchen and how did your cultural background influence your approach to health and wellness?
It was a combination for the love of food and wanting to stay healthy. I’m a total foodie at heart, and in the past, I falsely believed if you wanted to maintain a healthy shape or physique, it meant cutting out foods you love to eat, especially things like roti or aloo parathay. Coming from a South Asian background, these foods were what I ate growing up. So, I started first cooking for myself and started The Fit Kitchen to share my recipes so others could enjoy them too. Part of starting the Fit Kitchen is also to break the negative diet culture which can be misleading.
Indian food – is some of the BEST! I’ve started by taking some of my favorite childhood dishes and incorporating them into healthy meals that you can enjoy without sacrificing flavor. 2 3 4
Balancing a demanding career as a full-time Assistant Deputy Warden for BC Corrections with running The Fit Kitchen must require a lot of discipline. How do you manage both roles, and how has your experience in law enforcement influenced your approach to health and wellness?
Sometimes, it can be challenging. But both supplement each other and have only helped increase my discipline. Not only in this field, but any field, having a positive outlet is very important – and there’s no better outlet than a healthy lifestyle and routine. Over time, I learned to prioritize both and make it work like a healthy relationship, perhaps that’s what’s kept me going so long in this career to where I am now.
The gym is my outlet for my mental and physical health. But more importantly, the foods I eat and what I’m putting into my body. As a Nutrition Coach, how we treat our body – both inside and out – has a direct impact on how we manage stress, illnesses, and overall wellbeing and mental health.
In your role as an Assistant Deputy Warden, you’re likely exposed to highpressure situations. How do you maintain your mental and physical health in such a high-stress environment, and does this experience influence the type of wellness products and services you offer at The Fit Kitchen?
One word – the gym. The gym is my outlet for my mental and physical health. But more importantly, the foods I eat and what I’m putting into my body. As a Nutrition Coach, how we treat our body – both inside and out – has a direct impact on h ow we manage stress, illnesses, and overall wellbeing and mental health. My experience is to show people that you can do this with a full-time job that’s high stress – there’s always a way to make it fit. Part of the services I provide in the Fit Kitchen is personalized Coaching that’s catered to each person’s individual lifestyle. What works for me, may not work for you – therefore keeping that in mind, I cater to the individual needs and work directly with them to improve all aspects of their life.
Food and health play such a critical role in South Asian communities. How does The Fit Kitchen cater to both traditional flavors and modern nutritional needs?

This means making some healthy swaps and tweaking recipes to give you a wellrounded recipe that not only you can enjoy but will also support your fitness goals as well. If you follow me on Instagram – you will see I eat a lot of parathay lol.
How do you ensure the food you serve is both healthy and sustainable? Can you share some of the specific ingredients or techniques you use?
It really depends on the dish – but incorporating Protein is my first step in any dish I create. Protein is, in my view, the Super Macro. By adding more Protein – you can significantly support weight and fat loss, feel fuller longer, build muscle, boost metabolism, and it supports the immune system.
So I start with seeing how I can boost the Protein in any dish I create – then work on the other macros to create balanced meals.
What are some of the most popular dishes or meals at The Fit Kitchen that you love to share, and what makes them stand out in terms of both flavor and health benefits?
Oh gosh! Definitely my parathay with raita. By making some simple swaps, I can enjoy a full meal for about 440 calories with over 40 grams of protein and it hits the spot every time. – one of my personal favorites too. But really, most of my dishes have been well received by many. I feel very fortunate to have such a positive response.
Icanenjoyafullmeal for about 440 calories withover40gramsof proteinandithitsthe spoteverytime.–one ofmypersonalfavorites too.Butreally,mostof mydisheshavebeen wellreceivedbymany. Ifeelveryfortunate tohavesuchapositive response 6 7
In today’s society, there’s a lot of pressure to achieve a ‘beach body’ or a certain standard of physical appearance, especially as summer approaches. How do you navigate the conversation around body image and insecurities, both personally and through your business at The Fit Kitchen? What message would you like to share with people who may feel overwhelmed by these unrealistic standards?
I have said it before and will say it again – I am completely against the terms “beach body” or “bikini body” etc. I feel there’s so much negative diet culture on social media that really messes with people’s mentality about how you are supposed to look and I am
8
completely against it. For anyone I work with and having these conversations, my goal for anyone is to be able to look in the mirror and be happy with what you see back – no matter the shape and size. The scale is just a number, it doesn’t matter. What matters is how much energy you have, how you feel when you look in the mirror, your overall happiness, and mentally knowing you are in a good place.
You’ve created a brand focused on healthy living. What does a typical day in your life look like, and how do you prioritize your own health amidst your busy schedules?
I always start with a healthy breakfast of Oatmeal and Egg whites – it my absolute favorite.

But my routine is generally the same whether I’m at work or on days off. I prioritize my sleep, wake up and have a healthy breakfast, make time for the gym and or meal prep (depending on the day). If I am working, I make sure to pack all my food and snacks for long shifts, if I am on a day off, then I make sure to meal prep so I am prepared for the week. But it’s all about balance and making things fit. Some days can be busy, but for the most part, because I enjoy cooking – it doesn’t feel like work.
What does the term “health” mean to you, and how do you integrate it into your daily life, both personally and professionally?
Health to me means having a good balance, not restricting foods, and listening to my body. While for the most part, I maintain a great balance between work, prepping, gym, and my lifestyle – but I also enjoy a glass of wine with friends, or spending time with my pets and loved one. There’s a saying that food is fuel – I believe it should be fun too.

Looking ahead, where do you see The Fit Kitchen in the next 5 years? Are there any new projects or expansions you’re excited about?
Truthfully… I really haven’t’ thought that far. I’d like to tell you that I’d love to see myself up there in followers, or podcasts, but I’m really just enjoying the ride. I get genuinely excited when people tell me I’ve helped them in some way, or they love my recipes! I’m still basking in that wonderful positivity. But yes, I would like to see my business grow and I would like to help people understand that you don’t need to eat chicken, rice, and broccoli just to lose weight, or give up carbs, or fast 16 hours a day. I want to raise the standards for bodies and that they don’t have to look the way they do on Instagram. Everyone should feel they are entitled to wear a bikini at the beach, and eat aloo parathay on Sundays. And that’s the message I’m slowly trying to spread.
























Courtesy of the Indo-Canadian Voice
“The Underdog: A Veterinarian’s Fight Against Racism and Injustice”—the explosive true story of courage, conviction, and a 13year battle against systemic racism in Canada’s veterinary profession— is now available on Amazon and through major retailers worldwide.
This urgent, unflinching book from Dr. Hakam Singh Bhullar recounts how an immigrant veterinarian’s dream of making animal care affordable to all sparked the longest human rights trial in Canadian history.



Dr. Bhullar was the first Indo-Canadian veterinarian to open a low-cost animal clinic in Vancouver. Over his career, he mentored immigrant veterinarians, expanded affordable care across the Lower Mainland, and led a landmark human rights case that reshaped Canada’s veterinary profession.
In 1995, Dr. Bhullar opened Vancouver’s first low-cost clinic, providing families in need, the homeless, and animal welfare groups with accessible care. His model quickly gained traction, training and mentoring new immigrant veterinarians along the way. But his success— and his challenge to the industry’s profitprotected norms—provoked fierce retaliation.
The British Columbia Veterinary Medical Association (BCVMA) launched a coordinated campaign of discriminatory licensing barriers, surprise inspections, and punitive complaints. What followed was a grueling legal fight that exposed systemic racism and ended in a landmark ruling and rare public apology.
“This book is not just about my story—it’s about the power of persistence, the importance of community, and the belief that justice can prevail, even when the odds are stacked against you,” said Dr. Bhullar.
The Underdog uncovers chilling details, including surveillance video of a senior BCVMA official declaring, “Gone are the days when you can go there with a torch and burn the place down. Quicker way.” It’s a stark reminder of how institutional bias can weaponize systems of power against those trying to create equity and inclusion. A documentary is also now available.
This book is more than a memoir—it’s a call to action for anyone who believes in fairness, access, and standing up to entrenched injustice. As racial inequities persist across North America, Dr. Bhullar’s story offers both a warning and a source of hope.
The book’s release is accompanied by the launch of www.DrBhullarVet.com, where readers can access resources, sign up for updates, and learn more about the broader movement sparked by this fight.


Hardeep Kaur Singh combines the wisdom of ancient teachings with the effectiveness of modern therapeutic approaches to guide individuals on a holistic journey of healing and self-discovery. With years of experience as a compassionate and multi-faceted professional, Hardeep offers a unique fusion of Eastern and Western therapies, fostering deep healing across mind, body, and soul. Her work empowers people to reconnect with their inner truth, unlocking transformative growth and authentic self-expression.
Through her integrative approach, Hardeep utilizes both energy healing and sound therapy to help clients release deep-seated emotions and reconnect with a grounded sense of peace and clarity. These modalities complement her background in social work, addressing the often-overlooked energetic and spiritual dimensions of healing, allowing for a more complete, embodied experience of wellness.
Hardeep’s mission is to support those seeking purpose, self-awareness, and a greater sense of alignment with their highest selves. Her unique combination of time-honored, Eastern healing practices and modern therapeutic techniques creates a deeply transformative experience, meeting clients wherever they are on their journey. Her person-centered, trauma-informed, and collaborative approach makes healing accessible, impactful, and lasting.
Let Hardeep’s expertise in energy psychology, sound therapy, and holistic healing guide you toward an empowered, harmonious, and more fulfilled life.




Based in Winnipeg, Manitoba, I have spent the last 12 years documenting unforgettable love stories through my lens. Weddings are more than events they are emotional journeys. That’s why my work blends creativity, storytelling, and cinematic artistry to craft photos and films that feel alive. From grand Indian weddings to elegant Western ceremonies, we capture all types of events across Canada and internationally. Every frame is designed to reflect your unique story.



